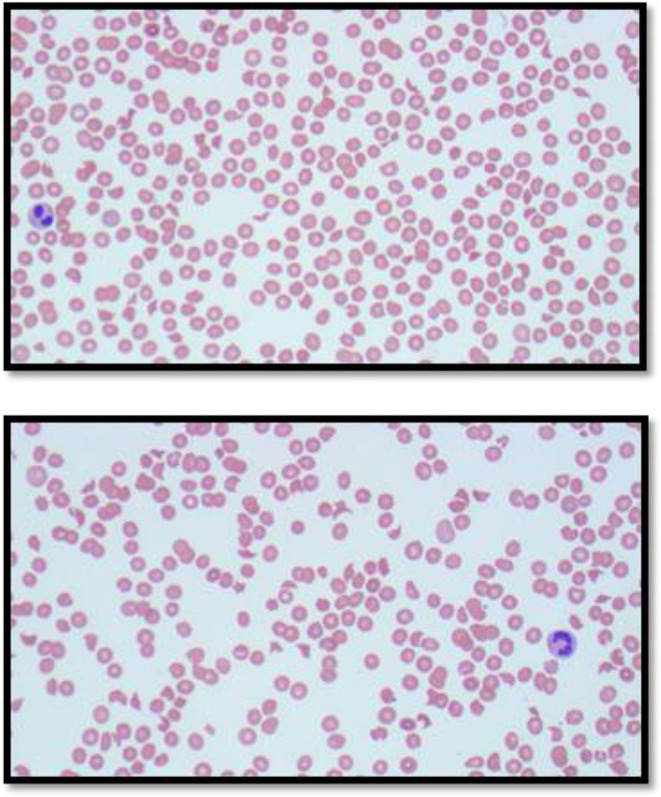

Respiratory Syncytial Virus Vaccine Induced Thrombotic Microangiopathy.
IF 2.7
Q3 HEMATOLOGY
Journal of Blood Medicine
Pub Date : 2025-07-22
eCollection Date: 2025-01-01
DOI:10.2147/JBM.S478230
引用次数: 0
Abstract
Microangiopathic hemolytic anemia with associated multiorgan failure is a medical emergency. The differential diagnosis for microangiopathic hemolytic anemia is broad and requires a systematic, focused approach at ruling out serious causes. However, with the rise of new vaccines and sporadic reports of vaccine-induced microangiopathic hemolytic anemia, it is essential for providers to include vaccines as a potential cause on their differential diagnosis. Here, we report the first case of respiratory syncytial virus vaccine-induced microangiopathic hemolytic anemia, anuric renal failure, and metabolic encephalopathy in the world.
呼吸道合胞病毒疫苗诱导血栓性微血管病。
微血管病溶血性贫血伴多器官功能衰竭是一种急症。微血管病溶血性贫血的鉴别诊断是广泛的,需要一个系统的、集中的方法来排除严重的原因。然而,随着新疫苗的兴起和疫苗引起的微血管病溶血性贫血的零星报道,提供者必须将疫苗作为其鉴别诊断的潜在原因。在这里,我们报告了世界上首例呼吸道合胞病毒疫苗引起的微血管病溶血性贫血、无尿性肾衰竭和代谢性脑病。
本文章由计算机程序翻译,如有差异,请以英文原文为准。
求助全文
约1分钟内获得全文
求助全文
来源期刊

Journal of Blood Medicine
HEMATOLOGY-
CiteScore
3.50
自引率
0.00%
发文量
94
审稿时长
16 weeks
期刊介绍:
The Journal of Blood Medicine is an international, peer-reviewed, open access, online journal publishing laboratory, experimental and clinical aspects of all topics pertaining to blood based medicine including but not limited to: Transfusion Medicine (blood components, stem cell transplantation, apheresis, gene based therapeutics), Blood collection, Donor issues, Transmittable diseases, and Blood banking logistics, Immunohematology, Artificial and alternative blood based therapeutics, Hematology including disorders/pathology related to leukocytes/immunology, red cells, platelets and hemostasis, Biotechnology/nanotechnology of blood related medicine, Legal aspects of blood medicine, Historical perspectives. Original research, short reports, reviews, case reports and commentaries are invited.
 求助内容:
求助内容: 应助结果提醒方式:
应助结果提醒方式:


